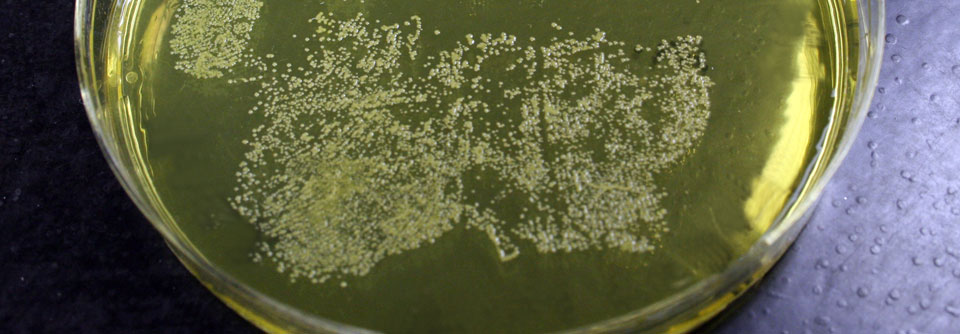

Neurodermitis: Mit Vitamin D die Basistherapie unterstützen
 Wer unter Neurodermitis leidet, kann den Erfolg seiner Therapie durch die Einnahme von Vitamin D verbessern.
© iStock/-aniaostudio-
Wer unter Neurodermitis leidet, kann den Erfolg seiner Therapie durch die Einnahme von Vitamin D verbessern.
© iStock/-aniaostudio-
Wer unter Neurodermitis leidet, kann den Erfolg seiner Therapie durch die Einnahme von Vitamin D verbessern. Dass dies nicht nur für moderate, sondern auch für schwere Formen gelten dürfte, zeigt eine kleine Studie mit 92 Probanden. Die Kinder und Jugendlichen im Alter von 5–16 Jahren hatten über zwölf Wochen zusätzlich zur zweimal täglichen Basistherapie mit einer 1 %igen Hydrokortison-Creme 1600 IU Vitamin D3 pro Tag oder ein Placebo erhalten. 86 Teilnehmer komplettierten die Studie.
Durchschnittliche Besserung um 56 %
Wie die ägyptischen Forscher um Dr. Noha O. Mansour von der Fakultät für Pharmazie der Universität Mansoura schreiben, stieg durch die Supplementierung nicht nur der Anteil der Kinder, die ausreichend mit Vitamin D versorgt waren, von 16 auf 93 %. Auch das Ausmaß der Ekzeme ging zurück. Der EASI*-Score, der den Schweregrad der Symptome und die Fläche der betroffenen Hautareale berücksichtigt, sank im Mittel um 56 % auf 20 Punkte.
Supplementierung nutzt längst nicht jedem
Unter Placebo reduzierte er sich zwar ebenfalls, aber nur um 42 % auf 27 Punkte. Die Vitamin-D-Spiegel lagen in der nicht- supplementierten Gruppe mit durchschnittlich knapp 26 ng/ml weiterhin überwiegend im insuffizienten Bereich.
Dennoch profitierten nicht alle von der täglichen Extraportion Vitamin D. So lag der Anteil der Non-Responder im EASI bei 59 % (52 % unter Placebo). Mit dem Vitamin ließen sich aber deutlich häufiger starke Verbesserungen um mindestens drei Viertel (EASI 75) vom Ausgangszustand erzielen: nämlich bei fast 40 % der Kinder – gegenüber 7% unter Placebo.
* Eczema Area and Severity Index
Quelle: Mansour NO et al. Pharmacol Res Perspect 2020; e00679; DOI: 10.1002/prp2.679